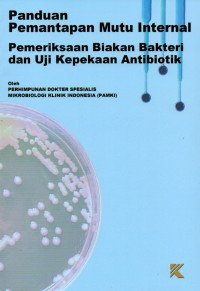
Image of Panduan Pemantapan Mutu Internal : Pemeriksaan Biakan Bakteri dan Uji Kepekaan Antibiotik

Text
Panduan Pemantapan Mutu Internal : Pemeriksaan Biakan Bakteri dan Uji Kepekaan Antibiotik
Tidak Tersedia Deskripsi
Ketersediaan
| FK02456 | 576 PER p | Perpustakaan Fakultas Kedokteran | Tersedia |
| FK02457 | 576 PER p | Perpustakaan Fakultas Kedokteran | Tersedia |
| FK02458 | 576 PER p | Perpustakaan Fakultas Kedokteran | Tersedia |
| FK02459 | 576 PER p | Perpustakaan Fakultas Kedokteran | Tersedia |
| FK02460 | 576 PER p | Perpustakaan Fakultas Kedokteran | Tersedia |
Informasi Detail
- Judul Seri
-
-
- No. Panggil
-
576 PER p
- Penerbit
- Pekanbaru : Taman Karya., 2023
- Deskripsi Fisik
-
xv; 87hlm; 24cm; ilus; bib
- Bahasa
-
Indonesia
- ISBN/ISSN
-
978-623-325-402-1
- Klasifikasi
-
576
- Tipe Isi
-
-
- Tipe Media
-
-
- Tipe Pembawa
-
-
- Edisi
-
Cetakan I, Januari 2023
- Subjek
-
-
- Info Detail Spesifik
-
-
- Pernyataan Tanggungjawab
-
-
Versi lain/terkait
Tidak tersedia versi lain
Lampiran Berkas
Tidak Ada Data
Komentar
Anda harus masuk sebelum memberikan komentar
 Karya Umum
Karya Umum  Filsafat
Filsafat  Agama
Agama  Ilmu-ilmu Sosial
Ilmu-ilmu Sosial  Bahasa
Bahasa  Ilmu-ilmu Murni
Ilmu-ilmu Murni  Ilmu-ilmu Terapan
Ilmu-ilmu Terapan  Kesenian, Hiburan, dan Olahraga
Kesenian, Hiburan, dan Olahraga  Kesusastraan
Kesusastraan  Geografi dan Sejarah
Geografi dan Sejarah